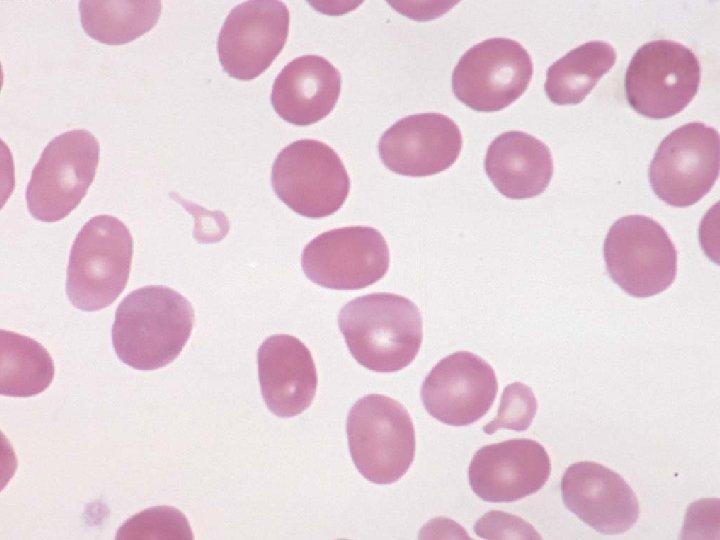
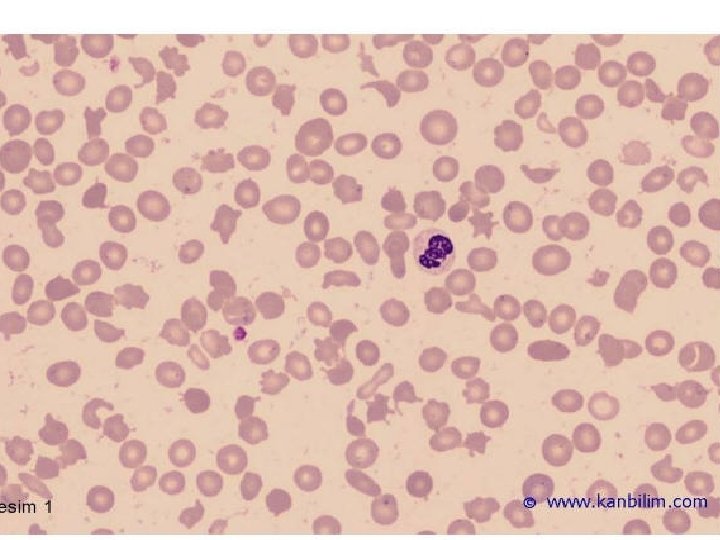
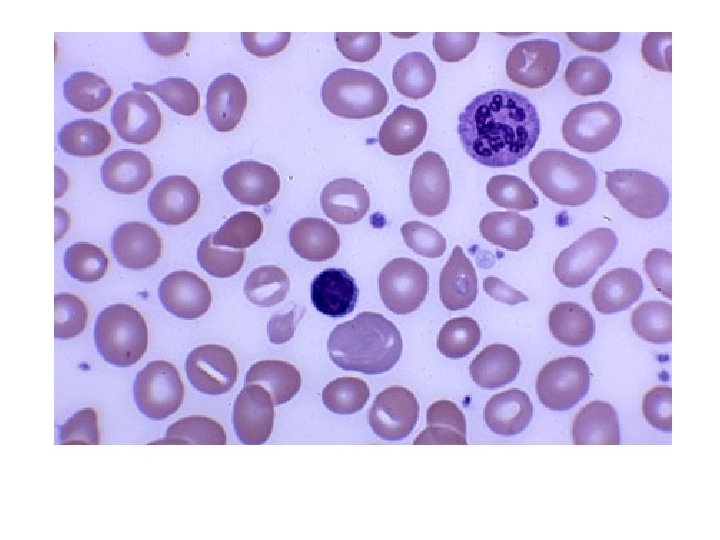
Dfsdf 38
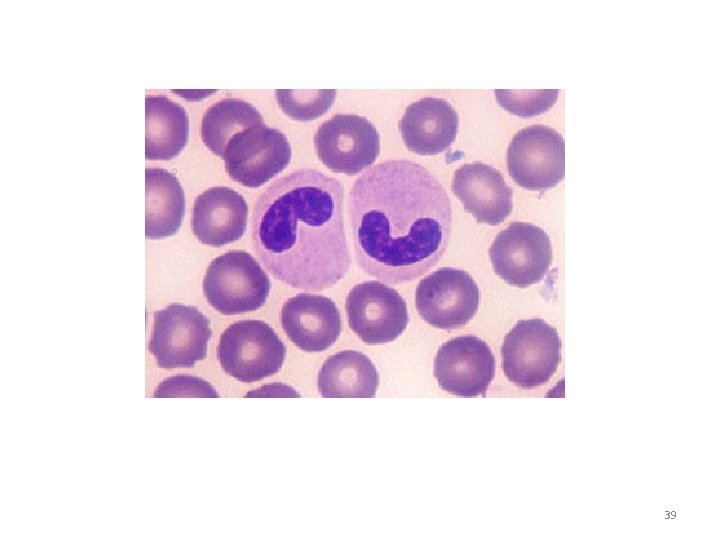
39

MYELODSPLASTK SENDROM NE KADAR FARKINDAYIZ Prof Dr H































































- Slides: 63

MYELODİSPLASTİK SENDROM: NE KADAR FARKINDAYIZ? Prof. Dr. H. İsmail SARI İç Hastalıkları ve Hematoloji Uzmanı E-mail: profdrhisari@gmail. com Web sayfası: https: //www. drhakanismailsari. com


65 yaş üstünde anemi %11 oranında gözlenmektedir. Anemi Tipi (%) 1. Nütrisyonel Faktör Eksikliği 34 Folat ve/veya B 12 14 Demir ve Folat ve/veya B 12 20 2. Kronik Hastalık 32 Yalnızca Kronik Böbrek Hastalığı 8 Yalnızca Kronik Hastalık Anemisi 20 Kronik Hastalık Anemisi ve Kronik Böbrek Hastalığı 4 3. Açıklanamayan 34

MYELODİSPLASTİK SENDROM (MDS): Niçin Hatırlamalıyız? • Tıp Fakültesi müfredatında genellikle yok • Diğer sitopeni nedenleri ile sıklıkla karışır • Yaşlı hastalarda atlanan bir hastalıktır • Yaşlı hastalarda insidansı oldukça yüksektir • Akut lösemiye dönüşüm 4

MDS: Nedir? • Klonal ve inefektif eritropoez • Morfolojik displazi • Periferik kanda sitopeni • Progresif kemik iliği yetmezliği ile karakterize • Akut lösemiye dönüşüm riski olan heterojen bir grup hastalığın ortak adıdır. 5

MDS: “yaşlı hastalığı” 70 Insidans (her 100, 000) 60 insidans 50 40 50 yaş altı 0. 5 50– 59 5. 3 60– 69 15 70– 79 80 yaş ve üstü 49 89 59 52 34 30 26 20 16 9 10 0 61 0 0 2 1 2 2 4 10 1 20– 25– 30– 35– 40– 45– 50– 55– 60– 65– 70– 75– 80– 85– 90– 95– yaş 6 Williamson PJ, et al. Br J Haematol. 1994; 87: 743 -5.

Türkiye’de MDS sıklığı biliniyor mu? • İnsidansı bilinmiyor –Avrupa verileri tahmin şansı verebilir –Toplumun daha genç bir yaş dağılımı olması fark oluşturabilir § Paydaş ve arkadaşları: Leuk Res 2006; 30: 362 -364 • Doğu ülkelerinde batıya göre 1 ya da 2 dekat daha erken görülmekte 7

MDS Karakteristik Özellikleri Ø İleri yaş Ø Erkeklerde daha sık Ø Tam kan sayımında sitopeniler Ø Anormal morfoloji Ø AML’ye dönüşüm Ø Kİ yetmezliği olguların çoğunda ölüm nedenidir. 8

PATOGENEZ • Myelodisplazi, myeloid kök hücrenin transformasyonun sonucudur. • Myeloid transformasyonda bir çok genetik mutasyonlar rol oynar. • Hastalığın en önemli işareti efektif olmayan hematopoezisdir.

MDS’ye Neden olan Faktörler • Herediter - Down Sendromu (trizomi 21) - Nörofibromatozis 1 - Familial monozomi 7 - Fanconi anemi - Ataksi-telenjiektazi - Fanconi anemisi - Bloom sendromu

MDS’ye Neden olan Faktörler • Akkiz - Akilleyici tedavi (melfalan, siklofosfamid, klorambucil) - Topoizomeraz inhibitörleri (antrasiklinler) - Çevresel/ mesleki (benzen) - Sigara - Aplastik anemi - Otolog kemik iliği transplantasyonu

Hikaye • • • Semptomların süresi Kan hastalığıyla ilgili geçmiş hikayesi Sitotoksik ajanlara maruziyet Medikal hikayesi Aşırı alkol alımı İlave hastalıklar

MDS- KLİNİK Ø Genellikle çok belirgin değildir Ø Olguların yaklaşık %50’si rutin kan sayımlarında tesadüfen saptanmaktadır Ø Semptomlar sıklıkla sitopenilere bağlıdır 13

MDS- KLİNİK Ø Anemi= • Anemiye bağlı yorgunluk en sık yakınmadır Ø Lökopeni= İnfeksiyon • Hastaların yaklaşık %30’unda tekrarlayan infeksiyon öyküsü vardır Ø Trombositopeni= • Trombositopeni sık görülse de kanama sık görülen bir bulgu değildir • Olguların %10’undan azında peteşi, purpura ve diğer kanama bulguları görülür 14

MDS- KLİNİK Ø Otoimmün ve romatolojik komplikasyonlar Ø Cilt bulguları= • Peteşi • Granulositik sarkom 15

MDS- KLİNİK Ø FM bulguları • • • Solukluk Peteşi Ekimoz İnfeksiyon bulguları Splenomegali LAP genellikle saptanmaz 16

MDS- LABORATUVAR • Tam Kan Sayımı • • • Anemi Lökopeni (Özellikle nötropeni) Trombositopeni Bisitopeni Pansitopeni • Olguların yaklaşık %50’si pansitopeniktir. 17

MDS- LABORATUVAR • Serum biyokimya profili • • LDH yüksekliği Ürik asit yüksekliği Serum Vit B 12 düzeyinde düşme İndirekt Bilirubin yüksekliği (Nadir) 18

Kan Tetkikleri • • Tam kan sayımı Periferik yayma Retikulosit sayısı Vit B 12 ve folik asit seviyesi Demir, demir bağlama kapasitesi, ferritin TSH LDH

Kemik İliği Testleri • • Aspirasyonda 200 hücrede blast oranı Auer body varlığı veya yokluğu Kemik iliği biyopside selulerite oranı Aspirasyonların demir ile boyanması ( ring sideroblast) • Kemik iliği biyopsinin demir ile boyanması

Kemik İliği Testleri • Displastik değişiklikler • Sitogenetik ( 20 metafaz hücresinin incelenmesi) • FİSH • Flowsitometri

Diğer Tetkikler • • ANA Coombs testi, haptoglobulin Serum eritropoetin seviyesi PNH taraması

MDS- LABORATUVAR Ø Periferik Yayma • Eritrositler • Makroovalositoz • Anizositoz • Nötrofiller • Hiposegmentasyon • Hipersegmentasyon • Granül yokluğu veya azlığı • Trombositler • Dev Trombositler 23

Eritrosit Hücreler • Periferik Yayma – Makrositoz – Gözyaşı hücreleri – Eliptosit – Akantosit

Eritrosit Hücreler • Kemik İliği Aspirasyon -Megaloblastik eritrosit öncü hücreleri -Eritrosit öncü hücrelerinde birden fazla nükleus -Eş zamanlı maturasyon göstermeyen nükleus ve sitoplazma - Nadir olarak sideroblastlar

Eritrosit Hücreler • Retikulosit index düşüktür. • Eritropoetin seviyesi normal veya yüksektir.


Myeloid Hücreler • Hastaların yaklaşık olarak %50’sinde nötropeni görülür. Periferik Yayma • Granulosit seride granülasyon ve lob sayısı azalmıştır. Kemik İliği Aspirasyon • Myeloid öncü hücrelerde eş zamanlı maturasyon göstermeyen nükleus ve sitoplazma • Myeloid öncü hücrelerin sitoplazmasında azalmış granüller.


Myeloid Hücreler • Nötrofillerin fonksiyonları bozuktur. Bundan dolayı akciğer, deri ve perianal bölge enfeksiyonları sık görülür. • Myeloblast oranı MDS hastalarında kritik öneme sahiptir. Hematopoetik kök hücrenin anormal farklılaşma kapasitesini gösterir. • AML tanısı, myeloblast oranı >%20 olması durumunda konur.

Megakoryosit • Trombositopeni hastaların yarısında görülür. • Trombosiztoz nadir olarak bulunur. (5 q sendromu ) • Trombosit fonksiyonları genellikle bozuktur. Cerrahi ve travma sonrası trombosit sayısı yeterli olsa bile kanama görülebilir.

Megakaryosit • Periferik Yaymada Büyük ve granülsüz trombositler • Kemik İliğinde Mikromegakaryositler ve nükleer lob sayısı azalmış megakaryositler • Birden fazla nükleusu olan (osteoklastlike)

Dfsdf 38
39

40


MDS- LABORATUVAR Ø Kemik İliği • Genelde Hiperselüler • Hiposellüler olabilir • Her üç seride yapısal bozukluklar (Displazi) 42

43

44

45

MDS tanı kriterleri A) Gerekli / olmazsa olmaz kriterler: 1. Eritroid, nötrofil, megakaryosit hücre serisinden bir veya daha fazlasında devam eden sitopeni olması gereklidir: – Hb<11 g/d. L, mutlak nötrofil sayısı<1. 500/μL, platelet <100. 000/ μL 2. Sitopeni veya displazi için primer neden olabilecek diğer hematopoietik veya non-hematopoietik bozuklukların dışlanması gereklidir. 46

MDS tanı kriterleri B) MDS ilişkili/ kesin kriterler: 1. Kemik iliğinde eritroid, nötrofil, megakaryosit serilerinden birinde en az %10 displazi veya kemik iliğinde >%15 ring sideroblast (demir boyası ile) olması gereklidir 2. Kemik iliğinde %5 -19 blast varlığı 3. Tipik kromozom anomali varlığı (+8, -7, 5 q-, 20 q-, diğerleri) (konvansiyonel veya FISH) 47

MDS-AYIRICI TANI 1. 2. 3. 4. 5. 6. 7. 8. Senil anemi Aplastik Anemi Paroksismal Nokturnal Hemoglobinüri Kronik Myeloproliferatif Hastalıklar HIV İlaçlar Besinsel Eksiklikler Kronik alkol alımı 48

FAB sınıflaması FAB Sınıflandırma Sistemi

Dünya Sağlık Örgütü (2008) MDS sınıflaması ALT TİP Periferik yayma Kemik İliği Tek dizide displazi ile seyreden refrakter sitopeniler(RCUD) Refrakter Anemi (RA) Refrakter Nötropeni (RN) Refrakter Trombositopeni (RT) Tek veya iki dizide sitopeni 1 Blast nadir veya yok (<%1) Tek dizide displazi; Etkilenen dizide ≥%10 displazi Blast <%5 Halka sideroblast <%15 Halka sideroblastlı refrakter anemi (RARS) Anemi var Blast yok Sadece eritroid displazi Halka sderoblast ≥%15 Blast <%5 Çoklu dizide displazili refrakter sitopeni (RCMD) Sitopeni(ler) Blast <%12 Auer cisimciği yok Monosit <1000/mm 3 ≥ 2 miyeloid dizide (nötrofil ve/veya eritroid öncül ve/veya megakaryosit) ≥ 10 displazi Blast <%5 Auer cisimciği yok ±%15 Halka sideroblast

Dünya Sağlık Örgütü (2008) MDS sınıflaması Alttip Periferik Yayma Kemik İliği Artmış blastlı refrakter anemi-I (RAEB-I) Sitopeni(ler) Blast <%5 Auer cisimciği yok Monosit <1000/mm 3 Tek veya çok dizide displazi %5 -9 blast 2 Auer cisimciği yok Artmış blastlı refrakter anemi-II (RAEB-II) Sitopeni(ler) Blast <%5 -19 Auer cisimciği ± 3 Monosit <1000/mm 3 Tek veya çok dizide displazi %10 -19 blast Auer cisimciği ± Sınıflanmamış MDS (MDS-U) Sitopeniler Blast <%12 Bir veya daha fazla miyeloid hücre dizisinde <%10 displazi Blast <%52 İzole del 5 q Anemi Çekirdeği az lobüllü normalsa Normal/artmış trombosit veya artmış megakaryosit sayısı Blast <%5 Blast <%1 izole del 5 q Auer cisimciği yok

Uluslararası prognostik skorlama sistemi Destek 0 0. 5 1 Kİ blast % <5 5 -10 - Karyotip* İyi Orta Kötü Sitopeni° 0/1 2/3 1. 5 2 11 -20 21 -30 *İyi: normal, -Y, del(5 q), del(20 q); Kötü: kompleks, 7. kromozom anomalileri; Orta : diğer anormalikler °Hemoglobin < 10 g/d. L, mutlak nötrofil < 1. 500/mm 3, trombosit< 100. 000/mm 3. Risk grupları için puanlar: Düşük = 0 Orta-1 = 0. 5 -1. 0 Orta-2, = 1. 5 -2. 0 Yüksek = 2. Blood 1997; 89: 2079 -2088

WHO sınıflamasını temel alan prognostik puanlama sistemi (“WPSS”)


MDS tedavisi: Nasıl yönetilmeli? DÜŞÜK --------------------ORTA--------------------YÜKSEK RİSK Yaşam kalitesini artırmak Sitopenileri düzeltmek Transfüzyon ihtiyacını azaltmak Destek tedavisi Doğal seyri değiştirerek sağkalımı uzatmak Allojenik nakil

MDS tedavisi: Tedavi Kararını Etkileyen Faktörler • Sağkalım beklentisi Hastalık ilişkili faktörler Risk grupları • Lösemiye dönüşüm riski • Yaş Hasta ilişkili faktörler • Komorbiditeler • İlaç etkileşimleri • Diğer risk skorlamaları

MDS tedavisi: Tedavi Kararını Etkileyen Faktörler Tanı Risk Skorlaması Tedavi Stratejisi

MDS – Destek Tedavi Ø Klinik monitorizasyon Ø Psikososyal destek Ø Yaşam kalitesinin değerlendirilmesi

MDS – Destek Tedavi Ø Transfüzyonlar Ø Semtomatik anemi: Eritrosit süspansiyonları Ø Trombositopenik kanama: Trombosit süspansiyonları Ø Eşik değer 10. 000 mm 3 Ø Işınlanmış ürünler: Transplant adayları için Ø CMV negatif kan ürünleri: CMV negatif transplant adayları için

MDS – Destek Tedavi Ø Antibiyotikler Ø Aminokaproik asid veya diğer antifibrinolitik ajanlar: Trombosit süspansiyonlarına dirençli kanamalarda veya uzamış trombositopenide Ø Demir şelasyonu Ø Deferoksamin ve deferasiroks Ø 20 -30 Ü eritrosit süspansiyonu Ø Düşük/Orta-1 risk grubu ve transplant adayı hastalar Ø Hedef: Ferritin<1000 Ø Kreatinin klerensi >%40

MDS – Destek Tedavi Ø Sitokinler Ø EPO Ø G-CSF ØRutin infeksiyon profilaksisinde önerilmez ØNötropenik hastalarda tekrarlayan ve dirençli infeksiyonda kullan ØEPO ile kombine kullanılabilir. ØTrombosit sayısı monitorize edilmeli

MDS-Tedavi 1. Destek tedavisi 2. İmmunsupresif tedavi 3. Diferansiyasyon tedavisi 4. Hipometile edici ajanlar 5. Sinyal iletim yolakları 6. Kök Hücre Transplantasyonu 62

SONUÇ • Olmazsa olmaz ve kesin kriterler mutlaka bilinmeli • Anemi, lökopeni, trombositopeni, bisitopeni ve pansitopeni tablosu ile gelen hastalarda (özellikle yaşlı hasta grubunda) • Vit B 12, demir tedavisine yanıtsız hastalarda • Özellikle yaşlılık anemisi olarak takip edilmiş ve ilerleyici sitopenisi olan hastalarda MDS AKILDA TUTULMALIDIR. . . 63